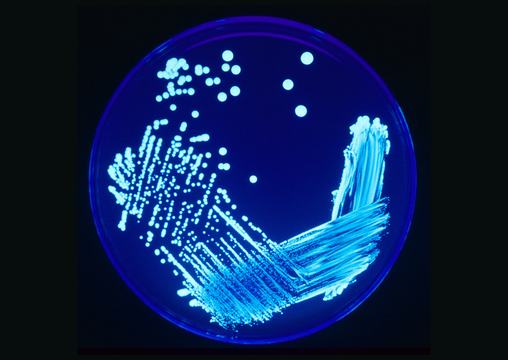

Több mint száz megbetegedést okozott New Yorkban a légiós betegség, fertőzött légkondicionálók miatt terjedhetett a fertőzés.
Öt ember meghalt, 14 kórházba került, miután légiós betegséggel fertőződtek meg New York Harlem negyedében, valószínűleg a szennyezett légkondicionáló berendezések miatt – írja az AFP hírügynökség nyomán a France 24.
Augusztus 18-ig összesen 108 megerősített esetet regisztráltak, közölte a New York-i egészségügyi hatóság. Miután több légkondicionáló hűtőtoronynál pozitív lett a Legionella baktériumra vonatkozó teszt, elrendelték a berendezések fertőtlenítését.

A légiós betegség egy életveszélyes tüdőgyulladást okozó fertőzés, amelyet a pangó vízben és klímaberendezésben szaporodó Legionella baktériumok okoznak.
A betegség elsősorban fertőzött, porlasztott vízcseppek belélegzésével terjed – emberről emberre, illetve ivóvíz fogyasztásával nem.
A baktérium lázat és tüdőgyulladás okozhat, különösen azoknál az embereknél, akiknek legyengült az immunrendszere.
A légiós vagy legionárius betegség nevét az első ismert járványról kapta, amely 1976-ban egy philadelphiai szállodában tört ki, ahol az American Legion katonai veteránok szövetsége tartott konferenciát. Akkor 34 ember vesztette életét a fertőzés miatt.
































